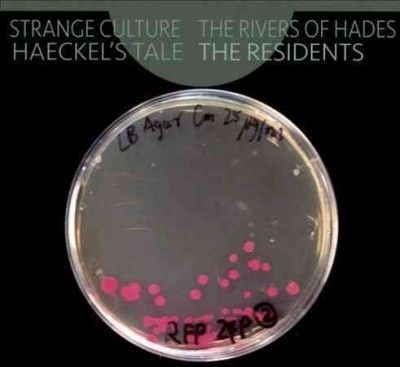
Strange Culture/Rivers of Hades/Haeckel's Tale (CD / Album)

Other Pop — Rivers
Browsing
Other Pop
More in Pop
One level up
More in Music
Shop by theme
No matches
Browsing
Other Pop
More in Pop
One level up
More in Music
Shop by theme
No matches
Baby & Toddler
Explore subcategories or shop the full department.

Beauty
Explore subcategories or shop the full department.

Cameras
Explore subcategories or shop the full department.

Camping & Outdoors
Explore subcategories or shop the full department.

Cellphones & Wearables
Explore subcategories or shop the full department.

Christmas
Explore subcategories or shop the full department.

Computers & Tablets
Explore subcategories or shop the full department.

Electronics
Explore subcategories or shop the full department.
Fashion
Explore subcategories or shop the full department.

Gaming
Explore subcategories or shop the full department.

Garden Pool & Patio
Explore subcategories or shop the full department.

Health
Explore subcategories or shop the full department.

Home & Kitchen
Explore subcategories or shop the full department.

Legacy PID redirect category 69cb99e894dba
Explore subcategories or shop the full department.
No subcategories yet — use “Shop all” to browse this department.
Luggage & Travel
Explore subcategories or shop the full department.

Movies & Series
Explore subcategories or shop the full department.

Current filter
Other Pop
More in Pop
One level up
More in Music
All Music
Music
Explore subcategories or shop the full department.

Office & Stationery
Explore subcategories or shop the full department.

Pets
Explore subcategories or shop the full department.

Sport
Explore subcategories or shop the full department.

Toys
Explore subcategories or shop the full department.

TV Audio & Video
Explore subcategories or shop the full department.

Vouchers
Explore subcategories or shop the full department.

Select a match from the list on the left.
Strange Culture/Rivers of Hades/Haeckel's Tale (CD / Album)
compare_arrows Compare at 2 storesR329.00
You've reached the end of the results.